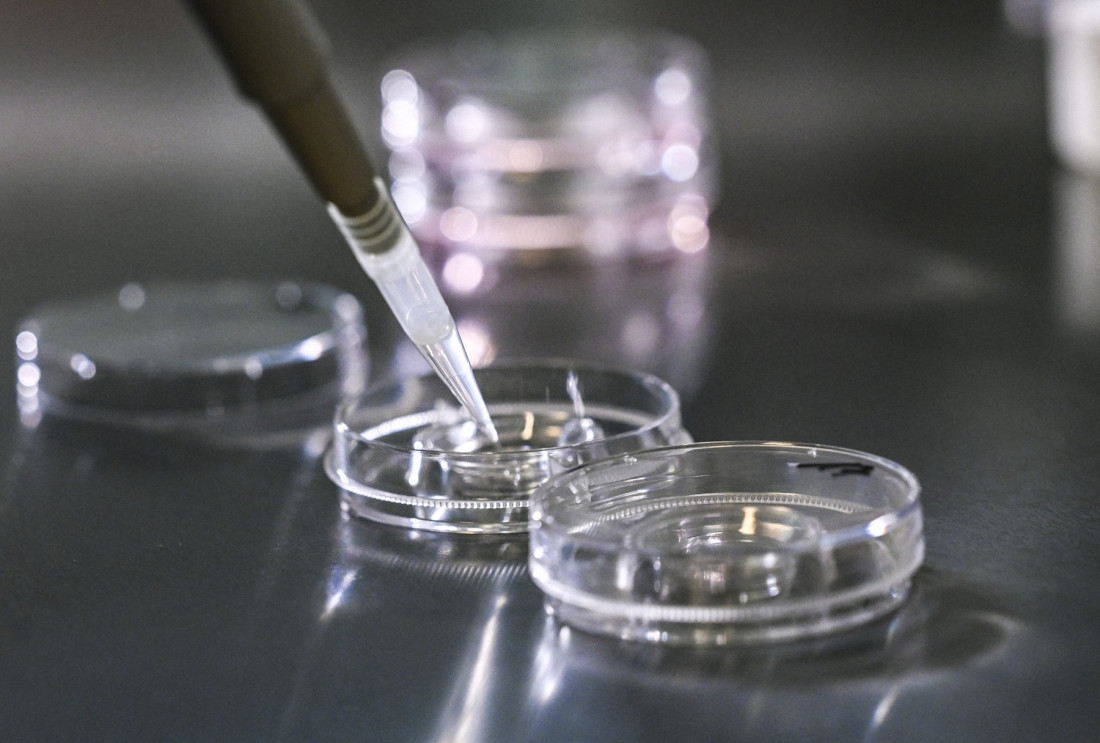

Nova šansa za roditeljstvo: Čačak ukinuo starosnu granicu za vantelesnu oplodnju - kako je u ostatku Srbije
KomentariGrad Čačak doneo je odluku da više ne postoji starosna granica za parove koji pokušavaju da postanu roditelji putem vantelesne oplodnje. Više nije ograničen ni broj pokušaja, a Grad je takođe povećao i novčana sredstva kojim će pomoći taj postupak.
Gradsko veće Grada Čačka je usvojilo pravilnik kojim se uređuju kriterijumi, postupak i visina za finansijsku pomoć za vantelesnu oplodnju.
"Sve u cilju da nas bude više, da podržimo na ovaj način i pronatalitetnu politiku koju sprovodi Vlada Republike Srbije. Ono što je najvažnije je da ne postoji ograničenje u broju biomedicinski potpomognutog oplođenja, bez obzira na to koliko je pokušaja do sada bilo ili koliko planiraju", kazao je za Euronews Srbija načelnik Gradske uprave za stručne poslove Skupštine Čačka Miroslav Petković.
Dodao je da ne postoji starosna granica i da se to odnosi i na žene koje su starije od 45 godina bez obzira na to da li nemaju decu ili imaju jedno dete.
"Za žene mlađe od 45 godina, koje imaju jedno dete, je bitno da su iskoristile sve mogućnosti koje pruža Republički fond za zdravstveno osiguranje", rekao je.
Napomenuo je da parovi mogu da biraju zdravstvenu ustanovu u kojoj će ostvariti ovu mogućnost, kako u zemlji, tako i u inostranstvu.
"Iznos sredstava koji je predviđen je do 450.000 dinara po paru i on se isplaćuje jednokratno. Nakon sprovedene procedure, parovi su u obavezi da u roku najdalje od šest meseci dostave potrebnu dokumentaciju i račune i novac će im biti isplaćen", objasnio je.
Naveo je da je prošle godine Grad Čačak imao tri zahteva za ovakvu proceduru. Dodao je da će Grad Čačak uvek naći mogućnost da parovi koji dobiju dete ovim putem dobiju i sredstva.
"Parovi mogu da se jave u Gradsku upravu za stručne poslove Skupštine, gradonačelnika i Gradskog veća. Postoje službenici koji se time bave. To je na drugom spratu, kancelarija broj 207. Uvek mogu da dođu, da se raspitaju. Mi ćemo im pomoći u prikupljanju dokumentacije i uputiti ih u čitavu proceduru. I nadam se da će mnogi parovi iskoristiti ovu mogućnost", zaključio je za Euronews Srbija Miroslav Petković.

Euronews
Grad je na poslednjoj sednici Gradskog veća doneo i odluke o povećanju iznosa koji se daje za prvo, drugo, treće i četvrto dete.
Starosna granica za vantelesnu oplodnju u Kragujevcu, Kraljevu u opštini Blace
U ostalim delovima Srbije granica za vantelesnu oplodnju je 45. godina. Međutim, u pojedinim gradovima ova granica je pomerena i do 50 godina.
Kragujevac
Na sednici Skupštine grada Kragujevca u julu 2024. godine starosna granica za žene za vantelesnu oplodnju je podignuta na 49 godina. Umesto dva, lokalna samouprava finansiraće tri pokušaja biomedicinski potpomognute oplodnje, kako bi se pružila mogućnost parovima da se ostvare kao roditelji. Istovremeno, za parove koji već imaju jedno dete zadržana su tri pokušaja do 47. godine.
Kraljevo i opština Blace
Kraljevo, ali i Opština Blace, sufinansiraju žene starosti i do 50 godina, preneli su ranije mediji.
Odluka Vlade o promeni starosne granice za vantelesnu oplodnju o trošku države
Inače, do jula 2022. godine u Srbiji je granica za vantelesnu oplodnju bila 43. godine kada je stupila na snagu odluka Vlade Srbije da se vantelesna oplodnja o trošku države omogući i ženama starosti do 45 godina, umesto do 43, kao što je do tada bio slučaj.
Pored pomeranja starosne granice za žene, proširivanjem prava uveden je i neograničeni broj krioembriotransfera za parove koji apliciraju na vantelesnu oplodnju radi dobijanja prvog deteta. Takođe, svi parovi koji u postojećoj zajednici imaju jedno dete, bez obzira na to da li je dete dobijeno prirodnim putem ili vantelesnom oplodnjom, imaju pravo na postupke vantelesne oplodnje radi dobijanja drugog deteta, što ranije nije bilo moguće.
JENS KALAENE/AFP/Profimedia

Svi parovi koji ispunjavaju uslove mogu da se prijave i izađu na komisijski pregled o trošku RFZO, i nakon toga izaberu neku od državnih ili privatnih klinika u kojima će biti sproveden postupak medicinski potpomognute oplodnje.
Svaki šesti par u Srbiji se bori za potomstvo
Pomeranje granice za vantelesnu oplodnju ili njeno ukidanje značajna je odluka s obzirom na to da se u Srbiji svaki šesti par bori za potomstvo, prema podacima koji su objavljeni 2023. godine. Borba za potomstvo koja traje duže od godinu dana, zahteva intervenciju lekara. Što se duže čeka, teži je prolazak kroz dalje procedure.
"Šanse za trudnoću po jednom ciklusu, kada imate jedan par između 25 i 30 godina koji su zdravi je 20 odsto po ciklusu, ali kumulativne šanse budu 85 odsto, što znači da posle godinu dana 85 odsto parova dobije dete. Kod žena sa 44 godine, mi bi trebalo da uradimo oko 350-400 ciklusa da bi dobili jednu trudnoću. I zato mi stalno naglašavamo da se ne čeka, da se to radi ranije, jer je sa godinama sve teže i taj biološki faktor za sada, ne postoji način da se prevaziđe", rekao je ranije ginekolog Milan Milenković za Euronews Srbija.

Komentari (0)